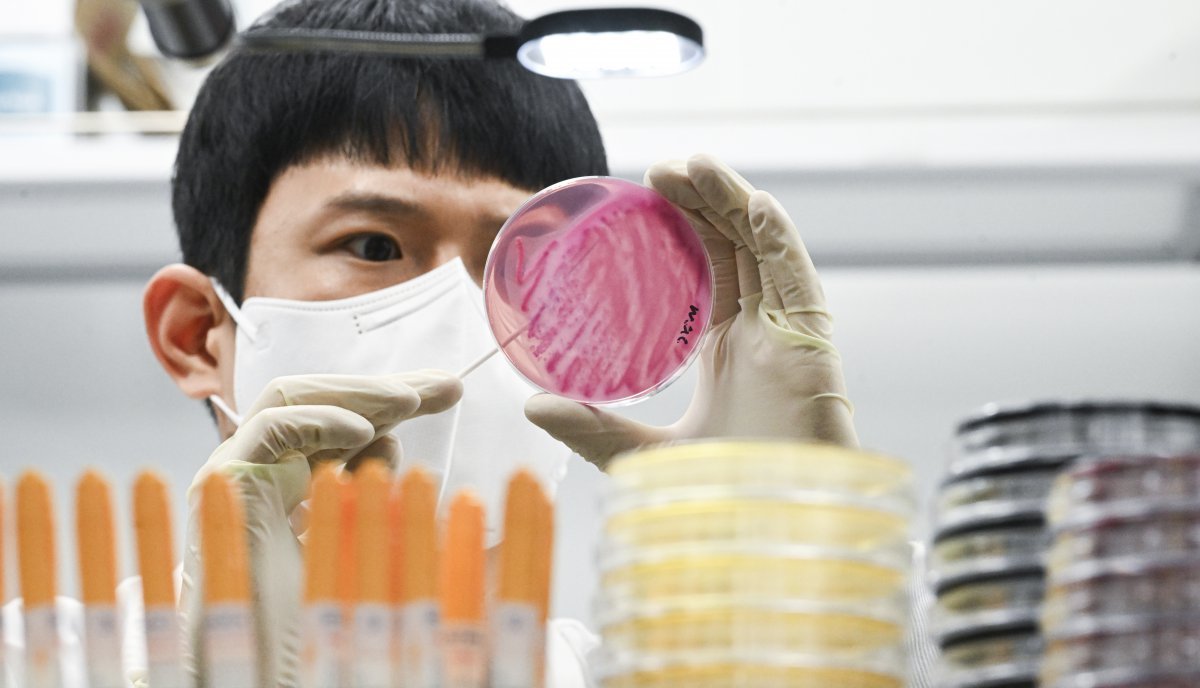

공유하기
인천 고교서 35명 설사·복통 ‘집단 식중독 의심’…역학조사 착수
- 뉴스1
-
입력 2025년 7월 3일 16시 45분
글자크기 설정
인천의 한 고등학교에서 학생 35명이 설사와 복통 등 식중독 의심 증상을 보여 인천시가 역학 조사에 착수했다.
3일 시에 따르면 인천시는 전날 해당 학교에서 관련 증상이 나타났단 신고를 접수하고 학생 36명의 검체와 급식 보존식을 채취해 원인 규명에 나섰다. 검사 결과는 2주 후 나올 예정이다.
학교 측도 급식실 등 교내 전 시설에 대한 긴급 소독을 마쳤다고 한다.
(인천=뉴스1)
트렌드뉴스
-
1
단순 잇몸 염증인 줄 알았는데…8주 지나도 안 낫는다면
-
2
부부 합쳐 6차례 암 극복…“내 몸의 작은 신호 잘 살피세요”
-
3
[이진영 칼럼]잘난 韓, 못난 尹, 이상한 張
-
4
“하루 3분이면 충분”…헬스장 안 가도 건강해지는 ‘틈새 운동’법
-
5
덴마크 언론 “폭력배 트럼프”… 英국민 67% “美에 보복관세 찬성”
-
6
취임 1년도 안돼 ‘명청 프레임’… 불쾌한 李, 정청래 면전서 경고
-
7
21시간 조사 마친 강선우 ‘1억 전세금 사용설’ 묵묵부답
-
8
韓은 참여 선그었는데…트럼프 “알래스카 LNG, 韓日서 자금 확보”
-
9
김정은, 공장 준공식서 부총리 전격 해임 “그모양 그꼴밖에 안돼”
-
10
결국 날아온 노란봉투…금속노조 “하청, 원청에 교섭 요구하라”
-
1
李대통령 “제멋대로 무인기 침투, 北에 총 쏜 것과 똑같다”
-
2
李대통령 “생리대 고급화하며 바가지…기본 제품 무상공급 검토”
-
3
‘평양 무인기 침투’ 尹 계획 실행한 드론사령부 해체된다
-
4
강선우, 의혹 22일만에 경찰 출석…“원칙 지키는 삶 살았다”
-
5
[이진영 칼럼]잘난 韓, 못난 尹, 이상한 張
-
6
정청래 “비법률가인 나도 법사위원장 했다”…검사 권한 고수 비판
-
7
李 가덕도 피습, 정부 공인 첫 테러 지정…“뿌리를 뽑아야”
-
8
[속보]李대통령 “무인기 침투, 北에 총 쏜 것과 똑같다”
-
9
의사 면허 취소된 50대, 분식집 운영하다 극단적 선택
-
10
“장동혁 죽으면 좋고” 김형주 막말에…국힘 “생명 조롱”
트렌드뉴스
-
1
단순 잇몸 염증인 줄 알았는데…8주 지나도 안 낫는다면
-
2
부부 합쳐 6차례 암 극복…“내 몸의 작은 신호 잘 살피세요”
-
3
[이진영 칼럼]잘난 韓, 못난 尹, 이상한 張
-
4
“하루 3분이면 충분”…헬스장 안 가도 건강해지는 ‘틈새 운동’법
-
5
덴마크 언론 “폭력배 트럼프”… 英국민 67% “美에 보복관세 찬성”
-
6
취임 1년도 안돼 ‘명청 프레임’… 불쾌한 李, 정청래 면전서 경고
-
7
21시간 조사 마친 강선우 ‘1억 전세금 사용설’ 묵묵부답
-
8
韓은 참여 선그었는데…트럼프 “알래스카 LNG, 韓日서 자금 확보”
-
9
김정은, 공장 준공식서 부총리 전격 해임 “그모양 그꼴밖에 안돼”
-
10
결국 날아온 노란봉투…금속노조 “하청, 원청에 교섭 요구하라”
-
1
李대통령 “제멋대로 무인기 침투, 北에 총 쏜 것과 똑같다”
-
2
李대통령 “생리대 고급화하며 바가지…기본 제품 무상공급 검토”
-
3
‘평양 무인기 침투’ 尹 계획 실행한 드론사령부 해체된다
-
4
강선우, 의혹 22일만에 경찰 출석…“원칙 지키는 삶 살았다”
-
5
[이진영 칼럼]잘난 韓, 못난 尹, 이상한 張
-
6
정청래 “비법률가인 나도 법사위원장 했다”…검사 권한 고수 비판
-
7
李 가덕도 피습, 정부 공인 첫 테러 지정…“뿌리를 뽑아야”
-
8
[속보]李대통령 “무인기 침투, 北에 총 쏜 것과 똑같다”
-
9
의사 면허 취소된 50대, 분식집 운영하다 극단적 선택
-
10
“장동혁 죽으면 좋고” 김형주 막말에…국힘 “생명 조롱”
-
- 좋아요
- 0개
-
- 슬퍼요
- 0개
-
- 화나요
- 0개



댓글 0